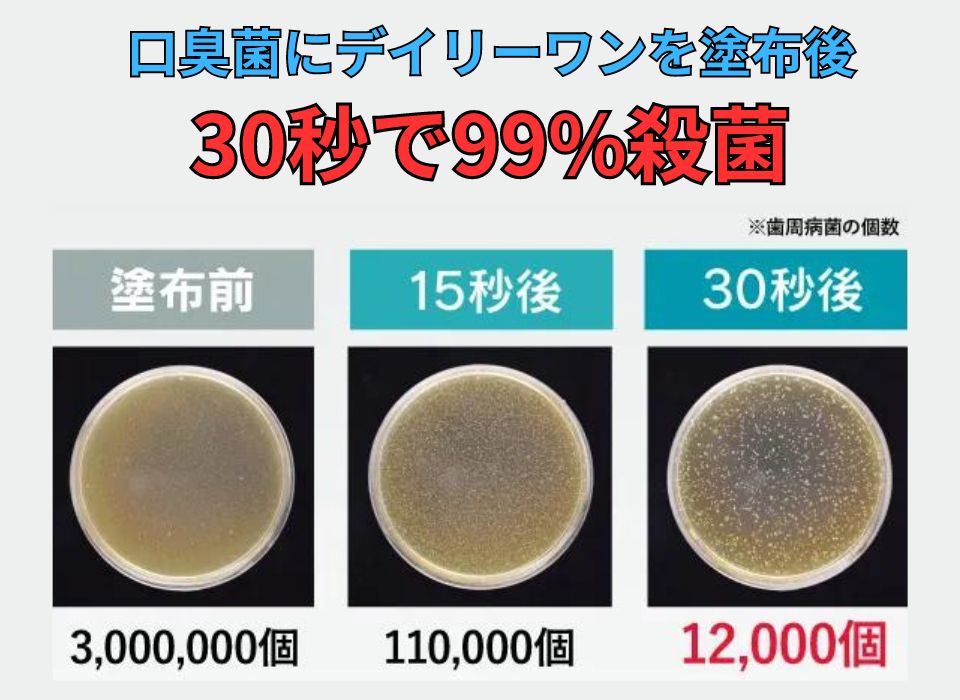

口臭の治し方をカンタン解説!
PR

口臭ケアできていますか?
マスク生活も終わり、至近距離で人と話すことも増えたことで「いま臭ってないかな…?」と不安になる方も多いかと思います。
そもそも口臭の原因はなんなのか、どんな治し方や対策があるのか。なるべくカンタンに分かりやすくご紹介していきます。
口臭の種類
まずは「なにが原因で不快なニオイが発生しているのか?」を理解しましょう。実は、口臭は大きく4つの種類に分けられます。
生理的口臭

寝起きや空腹時、緊張しているときに発生する口臭がこれに当たります。病気や体質に関係なく、健康な状態であったとしても誰もが多少はあるものです。食事や歯磨きで軽減します。
病的口臭

胃腸や肝臓など内蔵の不調が原因で発生する口臭です。最もたちが悪く、簡単にはニオイが治まりません。この記事でご紹介する正しいセルフケアで口臭が改善しなかった場合、医療機関の受診も検討されてください。
食べ物・嗜好品による口臭

にんにく、ネギなどの食材やお酒、コーヒー、タバコといった嗜好品の摂取によりひどい口臭が発生します。時間経過とともに軽減されるのが特徴です。
口の中に原因がある口臭

実際、口臭の原因のほとんどは口の中にあります。歯磨きでは落としきれない食べカスによって口臭が発生します。
口臭はセルフケアで治る?

原因は口の中にあることがほとんどなので、正しいセルフケアで口臭の発生を抑えることは可能です。
ただ、残念ながらあまり知られていない事実があります。
それは本当に口臭をなくす・予防するのであれば『歯磨きだけでは不十分』ということです。
ここから詳しく解説していきます!
歯磨きだけではダメな理由

そもそも口臭はタンパク質汚れが原因です。
(タンパク質汚れ=主に食べカス)
「ちゃんと歯磨してるから大丈夫」なわけではありません!!
実は、歯磨きで落とせる汚れは口全体のわずか25%…

残った汚れの中にはタンパク質汚れが大量に含まれています。

意外と知られていませんが、
このタンパク質汚れこそが諸悪の根源です。
意外と知らない『ニオイ発生のメカニズム』
口内の悪玉菌が口に残ったタンパク質汚れを分解することで悪臭の元となるガスを発生させます。これがいわゆる口臭です。

タンパク質汚れと悪玉菌を放っておくと、ひどい場合は歯周病やむし歯の原因にもなります。
そこまでいくと口臭がさらに強くなるという負のスパイラルに…

口臭を改善する2ステップ
だからこそ、口臭を改善するためには
『口内の殺菌&汚れを100%落とす』
という2ステップが必要になります。

この2ステップを同時にできる口臭対策グッズが『マウスウォッシュ』です。
即効性があり口臭予防にもなるので広く支持されています。
しかし、根本的な解決にならない気休め程度の商品もたくさんあるので、ちゃんと見極める必要があります。
マウスウォッシュなら何でもいい?→答えはNO!

市販のよくあるマウスウォッシュはマスキング効果というものを活用しています。
口臭に対して、その上からより強い香りを加えることで「口臭が消えた気がする」と一時的に錯覚させる効果です。
こういった商品では殺菌効果や汚れを100%落とす効果が見込めないどころか、場合によっては口臭と混ざって変なニオイになることも…

せっかくなら口臭の根本解決に繋がるマウスウォッシュを使いたいですよね。
なのでここからは正しい選び方と本当に効果のある商品のご紹介をしていきます!
\絶対に失敗しない!/
マウスウォッシュの選び方
①殺菌効果が厚労省に認められている医薬部外品を選ぶ
マウスウォッシュには大きく分けて化粧品・医薬部外品の2タイプがあります。
市販のマウスウォッシュには化粧品タイプが多く、口臭を根本から解決するような成分は配合されていません。スースーするだけで殺菌効果がない商品などがコレに当たります。

大前提として医薬部外品タイプを選びましょう。医薬部外品なら厚生労働省からも効果・効能が認可されています。
また、殺菌の有効成分としてはどちらか片方が入っていることを確認すればOKです。
- グリチルリチン酸ジカリウム ◎推奨
- アラントイン
②高濃度茶カテキンが入っているか
口臭対策に必要なのは口内の殺菌と同時にタンパク質汚れを落とすことです。
口内に残ったタンパク質汚れを固めて除去してくれる『高濃度茶カテキン』という成分が入っているか確認しましょう。

殺菌効果のある医薬部外品の中でも、高濃度茶カテキンは入っていないというケースは多いです。
しかし、口臭を根本的に解決したいなら必須と考えてください。
③歯のコーティング作用があるか
せっかく口内をキレイにしても、歯に汚れが付いてしまうと再び口臭が発生する原因になります。
コーティング作用のあるマウスウォッシュなら、汚れがつきにくくなって口臭予防になるだけでなくホワイトニング効果も期待できます。


以上のポイントを抑えておけばマウスウォッシュ選びでの失敗は防げます。
ただ、数ある商品の成分まで調べるのは大変ですよね…
そこで今回は私の方で売れ筋のマウスウォッシュ21商品を徹底リサーチしました!

その中から口臭への効果・クチコミ・コスパを基準におすすめTOP3を厳選してご紹介します。
【2025最新】口臭にはこれ!マウスウォッシュTOP3
 
| 
| 
| |
|---|---|---|---|
| 商品名 | デイリーワン | ブレスマイルウォッシュ | ゴッソトリノ |
| 評価 | 4.9 | 4.5 | 4.1 |
| 医薬部外品 |  |  |  |
| 汚れを落とす成分 |  高濃度茶カテキン |  高濃度茶カテキン |  なし |
| 殺菌成分 |  グリチルリチン酸ジカリウム |  アラントイン |  アラントイン |
| コーティング成分 | 2種類配合 | なし | 1種類配合 |
| 歯周病予防 |  |  |  |
| 臨床試験の有無 |  口臭菌を99%殺菌※2 |  |  口臭菌を強力殺菌 |
| 低刺激 |  植物由来成分 |  個人差あり |  植物由来成分 |
| 個包装 |  |  |  |
| 初回価格(税込) | →500円※1 | 980円 | 500円 |
※1 現在500円OFFクーポン配布中のため
※2 ユニオンバイテック調べ

- タンパク質汚れをごっそり除去できる
- 口臭の原因菌を99.9%殺菌※した研究結果
- 2種類のコーティング成分で口臭予防に
- 厚生労働省が認可した有効成分を配合
- 植物由来成分により低刺激で口に優しい(お子さんも使用可能)
- 初回500円で試せてコスパ良し◎
初回価格: 1,000円▶500円(税込)
※現在 半額クーポン配布中のため
送料 : 全国どこでも無料
定期縛り: なし いつでも解約OK
※ユニオンバイテック調べ
デイリーワンは口臭の原因菌を殺菌・洗浄する成分を配合した医薬部外品のマウスウォッシュです。

デイリーワンが支持されている秘密は
『即効性と殺菌力』にあります。
公開されている実験結果
※ユニオンバイテック調べ
サッと口臭ケアができるように1回分ずつ個包装になっているので、外に持ち歩く人も多いですし衛生面でも安心です。
さらに注目なのは”高濃度茶カテキン”を配合しているところ。
消臭効果が高いだけでなく、歯磨きでは落とせないタンパク質汚れを凝固しゴッソリ除去してくれます。

また、コーティング作用のある成分を2種類配合でしっかり口臭予防に。
植物由来成分で低刺激ながらホワイトニングや歯周病予防に有効な成分が豊富なのも特徴。

マウスウォッシュに欲しい機能がすべて備わっているところが凄いです!
それもそのはず。デイリーワンはニオイに特化した専門企業からも効果を認められています。

ランチ後にデイリーワンでうがいをしただけで「口臭がしっかりと抑えられている」結果に。

だからこそ、口臭に悩む方々から高い評価を得ています。
【デイリーワン】の口コミ
軽く口をゆすぐだけで口の中の汚れがびっくりするくらいに出てきました。ミント味ですがスースーするわけでもなく、刺激が少ないのも良いです。近距離での会話も怖くなくなったのが嬉しい! これからも愛用していきたいです。
個包装で持ち運びが楽なのが良いです♡全くピリピリせず、爽やかな後味なのもお気に入りポイント。歯磨きしたあとに使用しても汚れがごっそり出てくるのはびっくりでした!笑 お口の中がかなりスッキリ爽やかが持続するので、デート前とか仕事前にオススメです。
食後に使うだけでも随分とスッキリします。個包装されてるので気になった時に出先で使えるのも良い。ここまではっきりと汚れが見えるとは思っていなかったので、ブレスケアだけでなくブラッシングも以前よりも念入りにする習慣がついてきました。
※個人の感想であり効果効能を保証するものではありません。
SNSを中心に口コミがいっきに広がり、楽天ランキングでは何度も1位を獲得。
※自社調べ(2013年3月〜2021年9月実施より)

しかも歯科医院で採用されるほどの実力派!

人気・実力を十分に兼ね備えている商品です。しっかり効果を実感したい方は、デイリーワンを選んでおけば間違いありません。
初回価格: 1,000円▶500円(税込)
※現在 半額クーポン配布中のため
送料 : 全国どこでも無料
定期縛り: なし いつでも解約OK
\お得なクーポン配布中♪/
\1位のデイリーワン/
実際に使ってみました!
筆者の私もデイリーワンを愛用し始めました。
実際に使ってみると口の中が痛くならないし、ほどよく清涼感のあるミント味なので後味もスッキリ気持ちいいです。

見やすいようにコップに入れたんですが、普段はパウチから口に直接入れています。個包装だからコップ要らずなのが嬉しいですね♪
あと、吐き出したときに口の中の汚れがゴッソリ出てくるのは感動しました…!!
汚い画像なので申し訳ないのですが…↓↓↓

歯磨きはしっかりしてるのに、こんなに汚れが出てくるとは(笑)
使い始めてから口臭を気にせず快適に過ごせるようになったので、もう手放せません!
個人の意見ですがぜひ参考にされてください♪

- メディア掲載多数の有名商品
- 使用満足度96.7%
- 口臭ケア・歯槽膿漏・虫歯歯予防成分をバランス良く配合
- 初回980円で試せてコスパ良し◎
初回価格: 980円(税込)
定期縛り: なし
ブレスマイルウォッシュは殺菌成分のシメン-5-オールとアラントインがしっかり配合された人気商品です。

メディアでの掲載実績が豊富な有名商品で、歯槽膿漏・虫歯予防の成分が入っていることからクオリティは折り紙付き。

ただし、デイリーワンと違って個包装ではないのでご注意ください。
口コミではスッキリとした使用感が好評です。
【オーデント】の口コミ
個包装なので外食した後などに使えて便利です。味もスッキリとしていて口の中が清潔になるので続けたいです。
汚れが見えるほど落ちます。味も爽快感があって気持ちよく、寝る前や仕事の途中などリフレッシュできます。
夜寝る前に使用していますが、朝、口内がサッパリしてて驚きます。継続していきたいと思います。
※個人の感想であり効果効能を保証するものではありません。

- 製薬会社が開発した医薬部外品
- 口臭対策と虫歯&歯周病予防に
- 低刺激な使い心地
- 初回980円で試せてコスパ良し◎
初回価格: 980円(税込)
定期縛り: なし
口臭予防だけでなく、虫歯や歯周病予防、ホワイトニングにも期待ができる多機能なマウスウォッシュです。

低刺激にもこだわっており、15種類の植物由来成分が配合されています。

虫歯予防として愛用する方もいるようで、口コミでも高く評価されています。
【ゴッソトリノ】の口コミ
年齢のせいか口の中が乾きやすく、においが気になっていたので購入しました。使っていくうちに口の中の不快感も減って口臭も気にならなくなってきたのでオススメです。
口内環境にずっと不安があって痛くなったりしてましたが、この商品を使い始めてから前より減ったかなと思います!使いやすいし満足しています。
※個人の感想であり効果効能を保証するものではありません。
どれか迷ったら… デイリーワンがおすすめ!
デイリーワンがおすすめ!

- 口臭への有効成分がしっかり配合
- 99%殺菌の臨床試験結果あり※
- 累計販売数150万箱を突破
- ホワイトニング&歯周病予防にも◎
- コスパが良く気軽に試せる
※ユニオンバイテック調べ
コスパが良いうえに口臭への効果が強力なので、ここまで人気なのも頷けます。
歯科医でありタレントの中田彩さんが愛用していることでも注目されました。

口臭の対策に悩んできた私からするとデイリーワンが圧倒的に1位ですね。格安で試せるのも良いポイントです。
今なら公式サイトで約82%OFF
デイリーワンは定価5,581円(税込)ですが、
定期なら初回約82%OFFで試せます。
【公式サイト限定】5,581円▶1,000円(税込)
割引が適用されるのは公式サイトだけです。Amazonや楽天で買うと5,000円近く損してしまうのでご注意ください。

定期といってもいつでも解約OKなので、公式で買うのが1番お得です。
しかも、今ならさらに500円OFFになるクーポンが配布中です。
\初回の注文から使えます♪/

【クーポンを使ってさらに割引】5,581円▶1,000円▶500円(税込)
試すにはもってこいの時期です。安く手に入るうちにデイリーワンで口臭の悩みから解放されましょう!
\82%OFF&500円クーポン配布中/
※追記
デイリーワンは格安で試せることもあって、あまりの人気で一度は完売した商品です。

しばらくの間は予約販売のみで、すぐ手に入らない状態だったのですが…
今ならすぐ購入できます◎

ただ、いまだに人気なので今後は手に入らなくなる可能性はあります…。
買おうと思ったタイミングで完売していたら本当に嫌ですよね。
「あの時買っとけばよかった…」と後悔しないよう、お早めの確保をおすすめします。
\82%OFF&お得なクーポン配布中/
 
| 
| 
| |
|---|---|---|---|
| 商品名 | デイリーワン | ブレスマイルウォッシュ | ゴッソトリノ |
| 評価 | 4.9 | 4.5 | 4.1 |
| 医薬部外品 |  |  |  |
| 汚れを落とす成分 |  高濃度茶カテキン |  高濃度茶カテキン |  なし |
| 殺菌成分 |  グリチルリチン酸ジカリウム |  アラントイン |  アラントイン |
| コーティング成分 | 2種類配合 | なし | 1種類配合 |
| 歯周病予防 |  |  |  |
| 臨床試験の有無 |  口臭菌を99%殺菌※2 |  |  口臭菌を強力殺菌 |
| 低刺激 |  植物由来成分 |  個人差あり |  植物由来成分 |
| 個包装 |  |  |  |
| 初回価格(税込) | →500円※1 | 980円 | 500円 |
※1 現在500円OFFクーポン配布中のため
※2 ユニオンバイテック調べ


